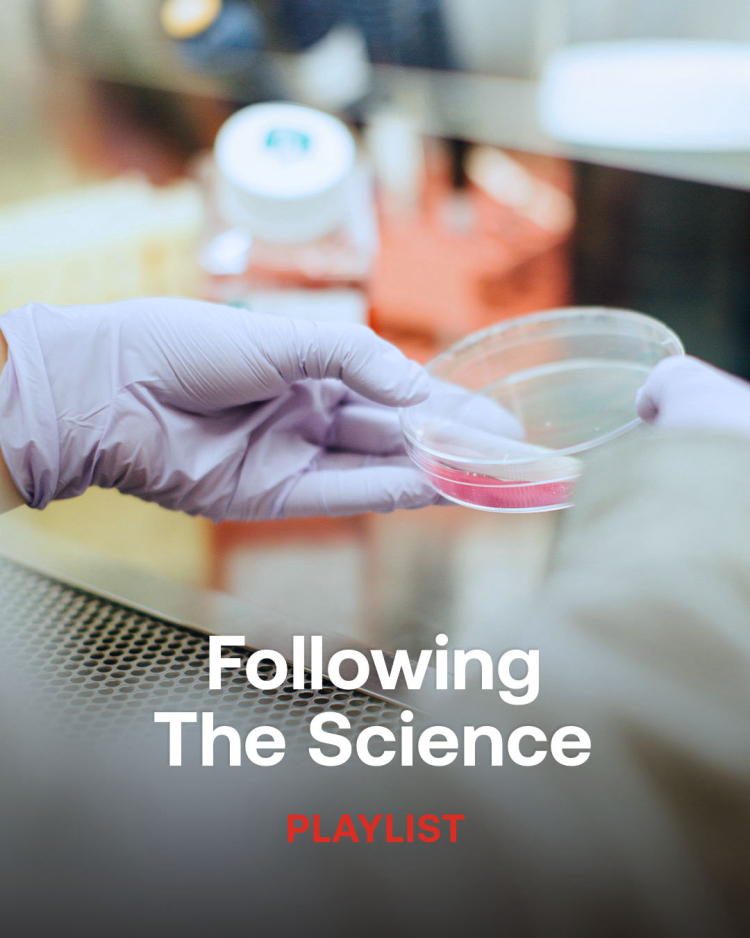
image alt text

Part music for scientific development and part soundtracks for hospitals, urgent responses and real-life drama, this playlist is the perfect companion for fly on the wall and factual programming about science, health and modern medicine

Part music for scientific development and part soundtracks for hospitals, urgent responses and real-life drama, this playlist is the perfect companion for fly on the wall and factual programming about science, health and modern medicine